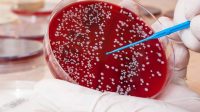
Penjelasan Lengkap Dokter Seputar Leukemia, Penyakit Ani Yudhoyono

Sarapan. Ilustrasi. Foto Trofoz PALU EKSPRES- – Bisa jadi karena tidak sempat atau malas, banyak…
Kesehatan
Catat 5 Anjuran Dokter Hindari Kelelahan Usai Mudik Berjam-jam Ilustrasi pemudik menggunakan kendaraan umum. Hindari…
Penjelasan Lengkap Dokter Seputar Leukemia, Penyakit Ani Yudhoyono
Ilustrasi kanker darah. Kanker darah atau blood cancer sendiri sebenarnya dibagi menjadi tiga yaitu leukemia,…
6 Manfaat Minum Seduhan Daun Peterseli Untuk Kesehatan
Minuman teh yang terbuat dari daun peterseli dipercaya membawa manfaat bagi kesehatan. Foto: The Cherry…
Jahe Bisa Atasi Mual dan Mabuk Perjalanan Mudik, Mitos Atau Fakta?
Ilustrasi mabuk dalam perjalanan mudik. Eevening Express. Foto: Eevening Express PALU EKSPRES – Mabuk atau…
4 Obat Alami Atasi Derasnya Darah dan Nyeri Haid
PALU EKSPRES – Biasanya kaum hawa mengalami jumlah darah haid atau menstruasi yang melimpah di…
Aroma dan Frekuensi Kentut Jadi Tanda Penyakit, Mitos atau Fakta?
PALU EKSPRES – Buang gas atau kentut tentu membuat orang lain tak nyaman. Mereka sampai…
7 Resolusi Perawatan untuk Dapatkan Kulit Glowing di 2019
PALU EKSPRES – Perawatan kulit bukan sekedar memakai krim siang dan malam, tetapi menambah rutinitas…
Tidak Ada Postingan Lagi.
Tidak ada lagi halaman untuk dimuat.